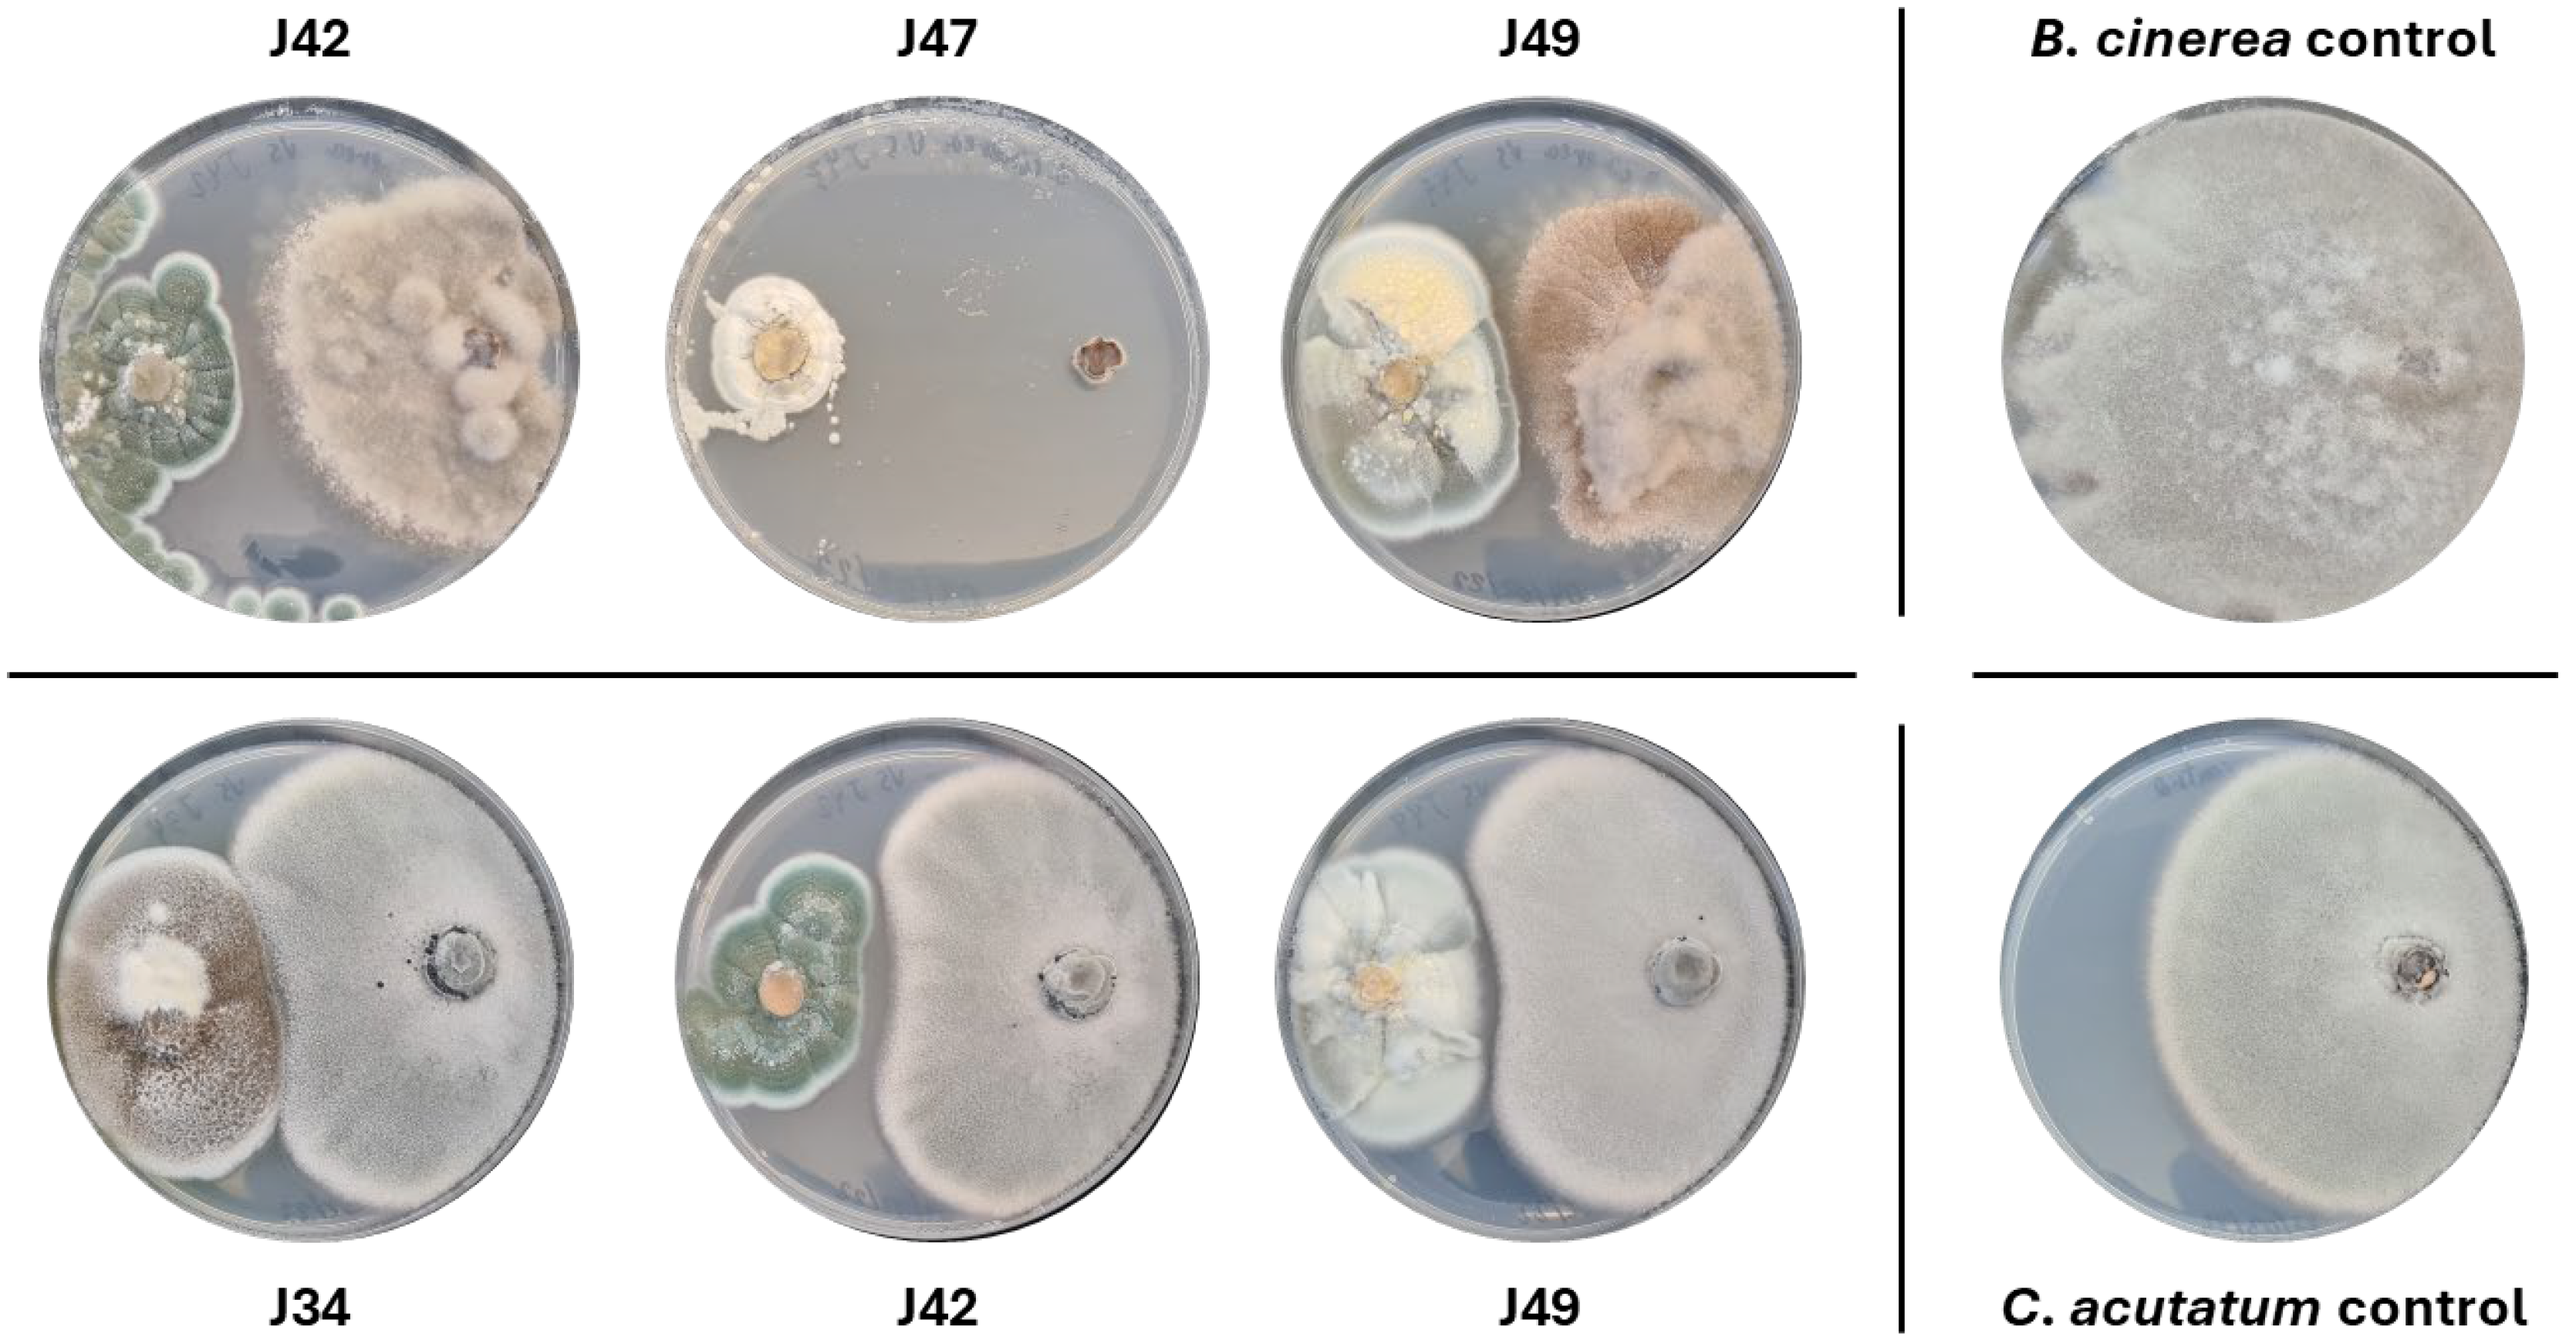
Agronomy 15 02711 g002

Multifunctional Endophytic Fungi from Ginger (Zingiber officinale) with Antimicrobial, Enzymatic, and Antioxidant Potential
Abstract
1. Introduction
2. Results
2.1. Isolation and Identification of Endophytic Fungi from Ginger
2.2. Antagonistic Activity Assays
2.2.1. Antifungal Activity of Endophytes Against Botrytis Cinerea B05.10 and Colletotrichum Acutatum IMI348489
2.2.2. Antibacterial Activity Against Staphylococcus aureus and Klebsiella pneumoniae
2.3. Enzymatic Activity Assays
2.4. Antioxidant Activity Assays
2.5. Antibacterial Activity of Endophytic Fungal Extracts
3. Discussion
3.1. Importance of Endophytic Microorganisms
3.2. Antagonistic Activity
3.3. Enzymatic and Antioxidant Activity
4. Materials and Methods
4.1. Isolation and Purification of Endophytic Fungi from Ginger Tubers
4.2. Morphological Characterization of Fungi
4.3. Molecular Characterization of Fungi
4.4. Antagonistic Activity Assays
4.4.1. Antagonistic Assays Against Botrytis Cinerea B05.10 and Colletotrichum Acutatum IMI348489
4.4.2. Antagonistic Assays Against Staphylococcus aureus and Klebsiella pneumoniae
4.5. Enzymatic Activity Assay of Endophytic Fungi
4.5.1. Amylolytic Activity Assay
4.5.2. Cellulolytic Activity Assay
4.5.3. Esterase Activity Assay
4.5.4. Lipolytic Activity Assay
4.5.5. Proteolytic Activity Assay
4.6. Fungal Fermentation, Extraction, and Assay of Crude Extracts
4.6.1. Fungal Cultivation and Liquid Phase Extraction of Metabolites
4.6.2. Antioxidant Activity Assay
4.6.3. Antibacterial Activity Assay of Crude Extracts
5. Conclusions
Supplementary Materials
Author Contributions
Funding
Data Availability Statement
Conflicts of Interest
References
- Harrison, J.G.; Griffin, E.A. The Diversity and Distribution of Endophytes across Biomes, Plant Phylogeny and Host Tissues: How Far Have We Come and Where Do We Go from Here? Environ. Microbiol. 2020, 22, 2107–2123. [Google Scholar] [CrossRef] [PubMed]
- Asad, S.; Priyashantha, A.K.H.; Tibpromma, S.; Luo, Y.; Zhang, J.; Fan, Z.; Zhao, L.; Shen, K.; Niu, C.; Lu, L.; et al. Coffee-Associated Endophytes: Plant Growth Promotion and Crop Protection. Biology 2023, 12, 911. [Google Scholar] [CrossRef] [PubMed]
- Chandra, H.; Yadav, A.; Prasad, R.; Kalra, S.J.S.; Singh, A.; Bhardwaj, N.; Gupta, K.K. Fungal Endophytes from Medicinal Plants Acting as Natural Therapeutic Reservoir. Microbe 2024, 3, 100073. [Google Scholar] [CrossRef]
- Fadiji, A.E.; Galeemelwe, O.; Babalola, O.O. Unravelling the Endophytic Virome Inhabiting Maize Plant. Agronomy 2022, 12, 1867. [Google Scholar] [CrossRef]
- Liao, C.; Doilom, M.; Jeewon, R.; Hyde, K.D.; Manawasinghe, I.S.; Chethana, K.W.T.; Balasuriya, A.; Thakshila, S.A.D.; Luo, M.; Mapook, A.; et al. Challenges and Update on Fungal Endophytes: Classification, Definition, Diversity, Ecology, Evolution and Functions. Fungal Divers. 2025, 131, 301–367. [Google Scholar] [CrossRef]
- Bolivar-Anillo, H.J.; González-Rodríguez, V.E.; Almeida, G.R.; Izquierdo-Bueno, I.; Moraga, J.; Carbú, M.; Cantoral, J.M.; Garrido, C. Endophytic Microorganisms as an Alternative for the Biocontrol of Phytophthora spp. In Agro-Economic Risks of Phytophthora and an Effective Biocontrol Approach; Intechopen: London, UK, 2021. [Google Scholar] [CrossRef]
- Gouda, S.; Das, G.; Sen, S.K.; Shin, H.S.; Patra, J.K. Endophytes: A Treasure House of Bioactive Compounds of Medicinal Importance. Front. Microbiol. 2016, 7, 219261. [Google Scholar] [CrossRef]
- Sharma, M.; Kansal, R.; Singh, D. Endophytic Microorganisms: Their Role in Plant Growth and Crop Improvement. In New and Future Developments in Microbial Biotechnology and Bioengineering: Crop Improvement Through Microbial Biotechnology; Elsevier: Amsterdam, The Netherlands, 2018; pp. 391–413. [Google Scholar] [CrossRef]
- Bolívar-Anillo, H.J.; Garrido, C.; Collado, I.G. Endophytic Microorganisms for Biocontrol of the Phytopathogenic Fungus Botrytis cinerea. Phytochem. Rev. 2020, 19, 721–740. [Google Scholar] [CrossRef]
- Nongalleima, K.; Dey, A.; Deb, L.; Singh, C.B.; Thongam, B.; Devi, H.S.; Devi, S.I. Endophytic Fungus Isolated From Zingiber zerumbet (L.) Sm. Inhibits Free Radicals And Cyclooxygenase Activity. Int. J. Pharmtech Res. 2013, 5, 301–307. [Google Scholar]
- Andriambeloson, H.O.; Rasolomampianina, R.; Ralambondrahety, R.; Andrianantenaina, R.; Raherimandimby, M.; Randriamiharisoa, F. Biological Potentials of Ginger Associated Streptomyces Compared with Ginger Essential Oil. Am. J. Life Sci. 2016, 4, 152–163. [Google Scholar] [CrossRef]
- Sudhakaran, G.; Chakraborty, S.; Kumar, A.; Bharti, S.A.K.; Csaba, V.; Valan Arasu, M.; Namasivayam, S.K.R.; Arockiaraj, J. Biochemical Insights into Diverse Psilocybe Mushrooms and Their Metabolites as Sources of Neuroactive Agents: A Review. Curr. Microbiol. 2025, 82, 386. [Google Scholar] [CrossRef]
- Avinash, G.P.; Namasivayam, S.K.R.; Pattukumar, V.; Priyanka, S. Microbial Biodegradation of Polyethylene Terephthalate Microplastics by an Indigenous Candida Tropicalis Strain and Biocompatibility Evaluation of Microplastics-Degraded Metabolites in GIFT Tilapia. 3 Biotech 2025, 15, 227. [Google Scholar] [CrossRef]
- Karthick Raja Namasivayam, S.; Arvind Bharani, R.S.; Samrat, K. Allochthonous Rhizobacterial Inoculation of Vigna radiata Promotes Plant Growth and Anti-Bacterial Metabolite Production. Biocatal. Agric. Biotechnol. 2024, 56, 103034. [Google Scholar] [CrossRef]
- Gupta, J.; Sharma, B.; Sorout, R.; Singh, R.G.; Ittishree; Sharma, M.C. Ginger (Zingiber officinale) in Traditional Chinese Medicine: A Comprehensive Review of Its Anti-Inflammatory Properties and Clinical Applications. Pharmacol. Res. Mod. Chin. Med. 2025, 14, 100561. [Google Scholar] [CrossRef]
- Oladosu, Y.; Rafii, M.Y.; Arolu, F.; Murugesu, S.; Chukwu, S.C.; Salisu, M.A.; Fagbohun, I.K.; Muftaudeen, T.K.; Kadar, A.I.; Oladosu, Y.; et al. Genetic Diversity and Utilization of Ginger (Zingiber Officinale) for Varietal Improvement: A Review. AIMS Agric. Food 2024, 9, 183–208. [Google Scholar] [CrossRef]
- Shahrajabian, M.H.; Sun, W.; Cheng, Q.; Shahrajabian, M.H.; Sun, W.; Cheng, Q. Pharmacological Uses and Health Benefits of Ginger (Zingiber officinale) in Traditional Asian and Ancient Chinese Medicine, and Modern Practice. Not. Sci. Biol. 2019, 11, 309–319. [Google Scholar] [CrossRef]
- Shahrajabian, M.H.; Sun, W.; Cheng, Q. Clinical Aspects and Health Benefits of Ginger (Zingiber officinale) in Both Traditional Chinese Medicine and Modern Industry. Acta Agric. Scand. B Soil. Plant Sci. 2019, 69, 546–556. [Google Scholar] [CrossRef]
- Mashhadi, N.S.; Ghiasvand, R.; Askari, G.; Hariri, M.; Darvishi, L.; Mofid, M.R. Anti-Oxidative and Anti-Inflammatory Effects of Ginger in Health and Physical Activity: Review of Current Evidence. Int. J. Prev. Med. 2013, 4, S36. [Google Scholar]
- Al-Awwadi, N.A.J. Potential Health Benefits and Scientific Review of Ginger. J. Pharmacogn. Phytother. 2017, 9, 111–116. [Google Scholar] [CrossRef]
- Owen, N.L.; Hundley, N. Endophytes—The Chemical Synthesizers inside Plants. Sci. Prog. 2004, 87, 79–99. [Google Scholar] [CrossRef]
- Ginting, R.C.B.; Sukarno, N.; Widyastuti, U.T.U.T.; Darusman, L.K.; Kanaya, S. Diversity of Endophytic Fungi from Red Ginger (Zingiber officinale Rosc.) Plant and Their Inhibitory Effect to Fusarium oxysporum Plant Pathogenic Fungi. Hayati 2013, 20, 127. [Google Scholar] [CrossRef]
- Suebrasri, T.; Somteds, A.; Harada, H.; Kanokmedhakul, S.; Jogloy, S.; Ekprasert, J.; Lumyong, S.; Boonlue, S. Novel Endophytic Fungi with Fungicidal Metabolites Suppress Sclerotium Disease. Rhizosphere 2020, 16, 100250. [Google Scholar] [CrossRef]
- Tenorio-Salgado, S.; Tinoco, R.; Vazquez-Duhalt, R.; Caballero-Mellado, J.; Perez-Rueda, E. Identification of Volatile Compounds Produced by the Bacterium Burkholderia tropica That Inhibit the Growth of Fungal Pathogens. Bioengineered 2013, 4, 236–243. [Google Scholar] [CrossRef] [PubMed]
- Abe, C.A.L.; Faria, C.B.; de Castro, F.F.; de Souza, S.R.; dos Santos, F.C.; da Silva, C.N.; Tessmann, D.J.; Barbosa-Tessmann, I.P. Fungi Isolated from Maize (Zea mays L.) Grains and Production of Associated Enzyme Activities. Int. J. Mol. Sci. 2015, 16, 15328. [Google Scholar] [CrossRef] [PubMed]
- Brand-Williams, W.; Cuvelier, M.E.; Berset, C. Use of a Free Radical Method to Evaluate Antioxidant Activity. LWT Food Sci. Technol. 1995, 28, 25–30. [Google Scholar] [CrossRef]
- Sridhar, K.; Charles, A.L. In Vitro Antioxidant Activity of Kyoho Grape Extracts in DPPH and ABTS Assays: Estimation Methods for EC50 Using Advanced Statistical Programs. Food Chem. 2019, 275, 41–49. [Google Scholar] [CrossRef]
- Mamangkey, J.; Mendes, L.W.; Mustopa, A.Z.; Hartanto, A. Endophytic Aspergillii and Penicillii from Medicinal Plants: A Focus on Antimicrobial and Multidrug Resistant Pathogens Inhibitory Activity. BioTechnologia 2024, 105, 83. [Google Scholar] [CrossRef]
- Potshangbam, M.; Devi, I.; Sahoo, D.; Strobel, G. Functional Characterization of Endophytic Fungal Community Associated with Oryza sativa L. and Zea mays L. Front. Microbiol. 2017, 8, 325. [Google Scholar] [CrossRef]
- Nair, D.N.; Padmavathy, S. Impact of Endophytic Microorganisms on Plants, Environment and Humans. Sci. World J. 2014, 2014, 250693. [Google Scholar] [CrossRef]
- Sabu, R.; Soumya, K.R.; Radhakrishnan, E.K. Endophytic Nocardiopsis sp. from Zingiber officinale with Both Antiphytopathogenic Mechanisms and Antibiofilm Activity against Clinical Isolates. 3 Biotech 2017, 7, 115. [Google Scholar] [CrossRef]
- Anisha, C.; Radhakrishnan, E.K. Metabolite Analysis of Endophytic Fungi from Cultivars of Zingiber officinale Rosc. Identifies Myriad of Bioactive Compounds Including Tyrosol. 3 Biotech 2017, 7, 146. [Google Scholar] [CrossRef]
- Pansanit, A.; Pripdeevech, P. Antibacterial Secondary Metabolites from an Endophytic Fungus, Arthrinium sp. MFLUCC16-1053 Isolated from Zingiber cassumunar. Mycology 2018, 9, 264–272. [Google Scholar] [CrossRef]
- Danagoudar, A.; Joshi, C.G.; Sunil Kumar, R.; Poyya, J.; Nivya, T.; Hulikere, M.M.; Anu Appaiah, K. Molecular Profiling and Antioxidant as Well as Anti-Bacterial Potential of Polyphenol Producing Endophytic Fungus-Aspergillus austroafricanus CGJ-B3. Mycology 2017, 8, 28–38. [Google Scholar] [CrossRef]
- Gupta, S.; Choudhary, M.; Singh, B.; Singh, R.; Dhar, M.K.; Kaul, S. Diversity and Biological Activity of Fungal Endophytes of Zingiber officinale Rosc. with Emphasis on Aspergillus terreus as a Biocontrol Agent of Its Leaf Spot. Biocatal. Agric. Biotechnol. 2022, 39, 102234. [Google Scholar] [CrossRef]
- Ding, C.; Wang, S.; Li, J.; Wang, Z. Transcriptomic Analysis Reveals the Mechanism of Host Growth Promotion by Endophytic Fungus of Rumex gmelinii Turcz. Arch. Microbiol. 2022, 204, 443. [Google Scholar] [CrossRef]
- Ap, A.; Wahyudi, A.; Ramadhan, F.; Widjajanti, H. Bioprospecting of Non-Mycorrhizal Endophytic Fungi Associated with Ferns and Mosses. Curr. Res. Environ. Appl. Mycol. J. Fungal Biol. 2021, 11, 416–437. [Google Scholar] [CrossRef]
- Barolo, M.I.; Castelli, M.V.; López, S.N. Antimicrobial Activity of Fungal Endophytes Associated with Peperomia argyreia (Piperaceae). Appl. Microbiol. 2024, 4, 753–770. [Google Scholar] [CrossRef]
- Roodi, D.; Millner, J.P.; McGill, C.R.; Johnson, R.D.; Hea, S.Y.; Brookes, J.J.; Glare, T.R.; Card, S.D. Development of Plant–Fungal Endophyte Associations to Suppress Phoma Stem Canker in Brassica. Microorganisms 2021, 9, 2387. [Google Scholar] [CrossRef]
- Chaturvedi, V.; DeFiglio, H.; Chaturvedi, S. Phenotype Profiling of White-Nose Syndrome Pathogen Pseudogymnoascus destructans and Closely-Related Pseudogymnoascus pannorum Reveals Metabolic Differences Underlying Fungal Lifestyles. F1000Research 2018, 7, 665. [Google Scholar] [CrossRef]
- Gomes, E.C.Q.; Gonçalves, V.N.; da Costa, M.C.; de Freitas, G.J.C.; Santos, D.A.; Johann, S.; Oliveira, J.B.S.; da Paixão, T.A.; Convey, P.; Rosa, L.H. Pathogenicity of Psychrotolerant Strains of Antarctic Pseudogmynoascus Fungi Reveals Potential Opportunistic Profiles. Microbe 2024, 5, 100186. [Google Scholar] [CrossRef]
- Luu, T.A.; Phi, Q.T.; Nguyen, T.T.H.; Van Dinh, M.; Pham, B.N.; Do, Q.T. Antagonistic Activity of Endophytic Bacteria Isolated from Weed Plant against Stem End Rot Pathogen of Pitaya in Vietnam. Egypt. J. Biol. Pest. Control 2021, 31, 14. [Google Scholar] [CrossRef]
- Campanile, G.; Ruscelli, A.; Luisi, N. Antagonistic Activity of Endophytic Fungi towards Diplodia corticola Assessed by In Vitro and in Planta Tests. Eur. J. Plant Pathol. 2007, 117, 237–246. [Google Scholar] [CrossRef]
- Zanudin, N.A.B.M.; Hasan, N.; Mansor, P.B. Antagonistic Activity of Fungal Endophytes Isolated from Garcinia atroviridis against Colletotrichum gloeosporioides. Hayati 2020, 27, 209–214. [Google Scholar] [CrossRef]
- Bustamante, M.I.; Elfar, K.; Eskalen, A. Evaluation of the Antifungal Activity of Endophytic and Rhizospheric Bacteria against Grapevine Trunk Pathogens. Microorganisms 2022, 10, 2035. [Google Scholar] [CrossRef] [PubMed]
- Al-Badi, R.S.; Karunasinghe, T.G.; Al-Sadi, A.M.; Al-Mahmooli, I.H.; Velazhahan, R. In Vitro Antagonistic Activity of Endophytic Fungi Isolated from Shirazi Thyme (Zataria multiflora Boiss.) against Monosporascus cannonballus. Pol. J. Microbiol. 2020, 69, 379–383. [Google Scholar] [CrossRef] [PubMed]
- Kushwaha, P.; Kashyap, P.L.; Srivastava, A.K.; Tiwari, R.K. Plant Growth Promoting and Antifungal Activity in Endophytic Bacillus Strains from Pearl Millet (Pennisetum glaucum). Braz. J. Microbiol. 2020, 51, 229–241. [Google Scholar] [CrossRef]
- Nia, R.; Mia, M.; Oktapiana, K. Antibacterial Activity Test of Endophytic Fungus from Mangrove Plant (Rhizophora apiculata L.) and (Bruguiera gymnorrizha (L.) Lamk.) Against Klebsiella pneumoniae ATCC 700603. KnE Life Sci. 2017, 2, 146–157. [Google Scholar] [CrossRef]
- Silva, D.P.D.; Cardoso, M.S.; Macedo, A.J. Endophytic Fungi as a Source of Antibacterial Compounds—A Focus on Gram-Negative Bacteria. Antibiotics 2022, 11, 1509. [Google Scholar] [CrossRef]
- Elmaidomy, A.H.; Shady, N.H.; Abdeljawad, K.M.; Elzamkan, M.B.; Helmy, H.H.; Tarshan, E.A.; Adly, A.N.; Hussien, Y.H.; Sayed, N.G.; Zayed, A.; et al. Antimicrobial Potentials of Natural Products against Multidrug Resistance Pathogens: A Comprehensive Review. RSC Adv. 2022, 12, 29078–29102. [Google Scholar] [CrossRef]
- Rosdee, S.; Wisessombat, S.; Tayeh, M.; Malakul, R.; Phanaksri, T.; Sianglum, W. Antibacterial Activity of the Endophytic Fungal Extracts and Synergistic Effects of Combinations of Ethylenediaminetetraacetic Acid (EDTA) against Pseudomonas aeruginosa and Escherichia coli. PeerJ 2025, 13, e19074. [Google Scholar] [CrossRef]
- Li, Y.; Kumar, S.; Zhang, L. Mechanisms of Antibiotic Resistance and Developments in Therapeutic Strategies to Combat Klebsiella pneumoniae Infection. Infect. Drug Resist. 2024, 17, 1107–1119. [Google Scholar] [CrossRef]
- Eshboev, F.; Mamadalieva, N.; Nazarov, P.A.; Hussain, H.; Katanaev, V.; Egamberdieva, D.; Azimova, S. Antimicrobial Action Mechanisms of Natural Compounds Isolated from Endophytic Microorganisms. Antibiotics 2024, 13, 271. [Google Scholar] [CrossRef] [PubMed]
- Bolívar-Anillo, H.J.; González-Rodríguez, V.E.; Cantoral, J.M.; García-Sánchez, D.; Collado, I.G.; Garrido, C. Endophytic Bacteria Bacillus subtilis, Isolated from Zea mays, as Potential Biocontrol Agent against Botrytis cinerea. Biology 2021, 10, 492. [Google Scholar] [CrossRef]
- Chávez-Avilés, M.N.; García-Álvarez, M.; Ávila-Oviedo, J.L.; Hernández-Hernández, I.; Bautista-Ortega, P.I.; Macías-Rodríguez, L.I. Volatile Organic Compounds Produced by Trichoderma asperellum with Antifungal Properties against Colletotrichum acutatum. Microorganisms 2024, 12, 2007. [Google Scholar] [CrossRef]
- Saravanakumar, K.; Lu, Z.; Xia, H.; Wang, M.; Sun, J.; Wang, S.; Wang, Q.Q.; Li, Y.; Chen, J. Triggering the Biocontrol of Botrytis cinerea by Trichoderma harzianum through Inhibition of Pathogenicity and Virulence Related Proteins. Front. Agric. Sci. Eng. 2018, 5, 271–279. [Google Scholar] [CrossRef]
- Kuzmanovska, B.; Rusevski, R.; Jankulovska, M.; Oreshkovikj, K.B. Antagonistic Activity of Trichoderma asperellum and Trichoderma harzianum against Genetically Diverse Botrytis cinerea Isolates. Chil. J. Agric. Res. 2018, 78, 391–399. [Google Scholar] [CrossRef]
- Iqbal, M.; Broberg, A.; Andreasson, E.; Stenberg, J.A. Biocontrol Potential of Beneficial Fungus Aureobasidium pullulans Against Botrytis cinerea and Colletotrichum acutatum. Phytopathology 2023, 113, 1428–1438. [Google Scholar] [CrossRef]
- Li, F.; Ghanizadeh, H.; Song, W.; Miao, S.; Wang, H.; Chen, X.; Liu, J.; Wang, A. Combined Use of Trichoderma harzianum and Clonostachys rosea to Manage Botrytis cinerea Infection in Tomato Plants. Eur. J. Plant Pathol. 2023, 167, 637–650. [Google Scholar] [CrossRef]
- Srinivas, C. Antimicrobial Activity and Phytochemical Analysis of Crude Extracts of Endophytic Fungi Isolated from Plumeria acuminata L. and Plumeria obtusifolia L. Pelagia Res. Libr. Eur. J. Exp. Biol. 2014, 4, 35–43. [Google Scholar]
- Desale, M.G.; Bodhankar, M.G. Antimicrobial Activity of Endophytic Fungi Isolated from Vitex negundo Linn. Int. J. Curr. Microbiol. App. Sci. 2013, 2, 389–395. [Google Scholar]
- Nwakanma, C.; Njoku, E.N.; T, P. Antimicrobial Activity of Secondary Metabolites of Fungi Isolated from Leaves of Bush Mango. J. Next Gener. Seq. Appl. 2016, 3, 1–6. [Google Scholar] [CrossRef]
- Mishra, R.; Kushveer, J.S.; Revanthbabu, P.; Sarma, V.V. Endophytic Fungi and Their Enzymatic Potential. In Advances in Endophytic Fungal Research; Springer: Cham, Switzerland, 2019; pp. 283–337. [Google Scholar] [CrossRef]
- Ashtekar, N.; Anand, G.; Thulasiram, H.V.; Rajeshkumar, K.C. Genus Penicillium: Advances and Application in the Modern Era. In New and Future Developments in Microbial Biotechnology and Bioengineering: Recent Advances in Application of Fungi and Fungal Metabolites: Current Aspects; Elsevier: Amsterdam, The Netherlands, 2021; pp. 201–213. [Google Scholar] [CrossRef]
- Abdel-Azeem, A.M.; Abo Nahas, H.H.; Abdel-Azeem, M.A.; Tariq, F.J.; Yadav, A.N. Biodiversity and Ecological Perspective of Industrially Important Fungi An Introduction. In Industrially Important Fungi for Sustainable Development; Springer: Cham, Switzerland, 2021; pp. 1–34. [Google Scholar] [CrossRef]
- Abdel-Azeem, A.M.; Abdel-Azeem, M.A.; Abdul-Hadi, S.Y.; Darwish, A.G. Aspergillus: Biodiversity, Ecological Significances, and Industrial Applications. In Recent Advancement in White Biotechnology Through Fungi. Fungal Biology; Springer: Cham, Switzerland, 2019; pp. 121–179. [Google Scholar] [CrossRef]
- Muñoz-Barrios, A.; Sopeña-Torres, S.; Ramos, B.; López, G.; Del Hierro, I.; Díaz-González, S.; González-Melendi, P.; Mélida, H.; Fernández-Calleja, V.; Mixão, V.; et al. Differential Expression of Fungal Genes Determines the Lifestyle of Plectosphaerella Strains During Arabidopsis thaliana Colonization. Mol. Plant Microbe Interact. 2020, 33, 1299–1314. [Google Scholar] [CrossRef]
- Zhan, F.X.; Wang, Q.H.; Jiang, S.J.; Zhou, Y.L.; Zhang, G.M.; Ma, Y.H. Developing a Xylanase XYNZG from Plectosphaerella cucumerina for Baking by Heterologously Expressed in Kluyveromyces lactis. BMC Biotechnol. 2014, 14, 107. [Google Scholar] [CrossRef] [PubMed]
- Martorell, M.M.; Ruberto, L.A.M.; Fernández, P.M.; De Figueroa, L.I.C.; Mac Cormack, W.P. Biodiversity and Enzymes Bioprospection of Antarctic Filamentous Fungi. Antarct. Sci. 2019, 31, 3–12. [Google Scholar] [CrossRef]
- Mengistu, A.A. Endophytes: Colonization, Behaviour, and Their Role in Defense Mechanism. Int. J. Microbiol. 2020, 2020, 6927219. [Google Scholar] [CrossRef]
- Bhadra, F.; Gupta, A.; Vasundhara, M.; Reddy, M.S. Endophytic Fungi: A Potential Source of Industrial Enzyme Producers. 3 Biotech 2022, 12, 86. [Google Scholar] [CrossRef]
- Jha, P.; Kaur, T.; Chhabra, I.; Panja, A.; Paul, S.; Kumar, V.; Malik, T. Endophytic Fungi: Hidden Treasure Chest of Antimicrobial Metabolites Interrelationship of Endophytes and Metabolites. Front. Microbiol. 2023, 14, 1227830. [Google Scholar] [CrossRef]
- Redkar, A.; Sabale, M.; Zuccaro, A.; Di Pietro, A. Determinants of Endophytic and Pathogenic Lifestyle in Root Colonizing Fungi. Curr. Opin. Plant Biol. 2022, 67, 102226. [Google Scholar] [CrossRef]
- Ibrahim, M.; Oyebanji, E.; Fowora, M.; Aiyeolemi, A.; Orabuchi, C.; Akinnawo, B.; Adekunle, A.A. Extracts of Endophytic Fungi from Leaves of Selected Nigerian Ethnomedicinal Plants Exhibited Antioxidant Activity. BMC Complement. Med. Ther. 2021, 21, 98. [Google Scholar] [CrossRef] [PubMed]
- Osman, M.E.; Abou-zeid, A.M.; Abu-Saied, M.A.; Ayid, M.M.; El-Zawawy, N.A. Diversity and Bioprospecting Activities of Endophytic Fungi Associated with Different Egyptian Medicinal Plants. Sci. Rep. 2025, 15, 19494. [Google Scholar] [CrossRef]
- Naveen, K.V.; Saravanakumar, K.; Sathiyaseelan, A.; Wang, M.H. Comparative Analysis of the Antioxidant, Antidiabetic, Antibacterial, Cytoprotective Potential and Metabolite Profile of Two Endophytic Penicillium spp. Antioxidants 2023, 12, 248. [Google Scholar] [CrossRef]
- Toghueo, R.M.K.; Boyom, F.F. Endophytic Penicillium Species and Their Agricultural, Biotechnological, and Pharmaceutical Applications. 3 Biotech 2020, 10, 107. [Google Scholar] [CrossRef]
- Strobel, G.; Daisy, B. Bioprospecting for Microbial Endophytes and Their Natural Products. Microbiol. Mol. Biol. Rev. 2003, 67, 491–502. [Google Scholar] [CrossRef]
- Shahid, M.; Hameed, S.; Tariq, M.; Zafar, M.; Ali, A.; Ahmad, N. Characterization of Mineral Phosphate-Solubilizing Bacteria for Enhanced Sunflower Growth and Yield-Attributing Traits. Ann. Microbiol. 2015, 65, 1525–1536. [Google Scholar] [CrossRef]
- Bolívar Anillo, H.J. Evaluación de La Capacidad Antifúngica y de Promoción de Crecimiento Vegetal de La Microbiota Endófita Aisladas de Plantas de Maíz (Zea mays) Así Como de Hongos Antagonistas Aislados de Otras Fuentes; Universidad de Cádiz: Cadiz, Spain, 2018. [Google Scholar]
- Garrido, C.; Carbú, M.; Fernández-Acero, F.J.; Vallejo, I.; Manuel Cantoral, J. Phylogenetic Relationships and Genome Organisation of Colletotrichum acutatum Causing Anthracnose in Strawberry. Eur. J. Plant Pathol. 2009, 125, 397–411. [Google Scholar] [CrossRef]
- White, T.J.; Bruns, T.; Lee, S.; Taylor, J. Amplification and Direct Sequencing of Fungal Ribosomal RNA Genes for Phylogenetics. In PCR Protocols: A Guide to Methods and Applications; Academic Press: New York, NY, USA, 1990; pp. 315–322. [Google Scholar]
- Cubeta, M.A. Characterization of Anastomosis Groups of Binucleate Rhizoctonia Species Using Restriction Analysis of an Amplified Ribosomal RNA Gene. Phytopathology 1991, 81, 1395. [Google Scholar] [CrossRef]
- Glass, N.L.; Donaldson, G.C. Development of Primer Sets Designed for Use with the PCR to Amplify Conserved Genes from Filamentous Ascomycetes. Appl. Environ. Microbiol. 1995, 61, 1323–1330. [Google Scholar] [CrossRef]
- Aly, A.H.; Debbab, A.; Kjer, J.; Proksch, P. Fungal Endophytes from Higher Plants: A Prolific Source of Phytochemicals and Other Bioactive Natural Products. Fungal Divers. 2010, 41, 1–16. [Google Scholar] [CrossRef]
- Sahani, K.; Thakur, D.; Hemalatha, K.P.J.; Ganguly, A. Antibacterial Activity Of Endophytes From Selected Medicinal Plants. Int. J. Adv. Res. 2017, 5, 2076–2086. [Google Scholar] [CrossRef]
- Powthong, P.; Jantrapanukorn, B.; Thongmee, A.; Suntornthiticharoen, P. Screening of Antimicrobial Activities of the Endophytic Fungi Isolated from Sesbania grandiflora (L.) Pers. J. Agric. Sci. Technol. 2013, 15, 1513–1522. [Google Scholar]
- Dias, A.C.F.; Andreote, F.D.; Dini-Andreote, F.; Lacava, P.T.; Sá, A.L.B.; Melo, I.S.; Azevedo, J.L.; Araújo, W.L. Diversity and Biotechnological Potential of Culturable Bacteria from Brazilian Mangrove Sediment. World J. Microbiol. Biotechnol. 2009, 25, 1305–1311. [Google Scholar] [CrossRef]
- Hankin, L.; Anagnostakis, S.L. The Use of Solid Media for Detection of Enzyme Production by Fungi. Oecologia 1975, 67, 597. [Google Scholar] [CrossRef]
- Kasana, R.C.; Salwan, R.; Dhar, H.; Dutt, S.; Gulati, A. A Rapid and Easy Method for the Detection of Microbial Cellulases on Agar Plates Using Gram’s Iodine. Curr. Microbiol. 2008, 57, 503–507. [Google Scholar] [CrossRef]
- Sierra, G. A Simple Method for the Detection of Lipolytic Activity of Micro-Organisms and Some Observations on the Influence of the Contact between Cells and Fatty Substrates. Antonie Van. Leeuwenhoek 1957, 23, 15–22. [Google Scholar] [CrossRef]
- Castro, R.A.; Quecine, M.C.; Lacava, P.T.; Batista, B.D.; Luvizotto, D.M.; Marcon, J.; Ferreira, A.; Melo, I.S.; Azevedo, J.L. Isolation and Enzyme Bioprospection of Endophytic Bacteria Associated with Plants of Brazilian Mangrove Ecosystem. Springerplus 2014, 3, 382. [Google Scholar] [CrossRef]
- Mtibaà, R.; Ezzanad, A.; Aranda, E.; Pozo, C.; Ghariani, B.; Moraga, J.; Nasri, M.; Manuel Cantoral, J.; Garrido, C.; Mechichi, T. Biodegradation and Toxicity Reduction of Nonylphenol, 4-Tert-Octylphenol and 2,4-Dichlorophenol by the Ascomycetous Fungus Thielavia sp HJ22: Identification of Fungal Metabolites and Proposal of a Putative Pathway. Sci. Total Environ. 2020, 708, 135129. [Google Scholar] [CrossRef]
- Cockerill, F.R.C.; Clinical and Laboratory Standards Institute. Methods for Dilution Antimicrobial Susceptibility Tests for Bacteria That Grow Aerobically: Approved Standard, 9th ed.; CSLI: Wayne, PA, USA, 2012; Available online: https://search.worldcat.org/es/title/894734842 (accessed on 25 July 2025).
- Gutiérrez-Escobar, R.; Fernández-Marín, M.I.; Richard, T.; Fernández-Morales, A.; Carbú, M.; Cebrian-Tarancón, C.; Torija, M.J.; Puertas, B.; Cantos-Villar, E. Development and Characterization of a Pure Stilbene Extract from Grapevine Shoots for Use as a Preservative in Wine. Food Control 2021, 121, 107684. [Google Scholar] [CrossRef]

| Isolate | Identification | GenBank Acc. N. | |
|---|---|---|---|
| ITS-5.8S rRNA | 28S rRNA | ||
| J34 | Aspergillus ustus | PV931932 | PP716837 |
| J35 | Aspergillus keveii | PP716609 | PP716758 |
| J36 | Penicillium chrysogenum | PV984452 | PP716759 |
| J42 | Penicillium steckii | PP716611 | PP716764 |
| J47 | Penicillium melinii | PP716612 | PP716766 |
| J48 | Aspergillus ustus | PP717821 | PP716771 |
| J49 | Penicillium citreonigrum | PP716615 | PP716804 |
| J55 | Pseudogymnoascus pannorum | PP717824 | PP716807 |
| HJ1 | Plectosphaerella cucumerina | PP716608 | PP716755 |
| Endophytes | % Inhibition of B. cinerea | % Inhibition of C. acutatum | % Inhibition of S. aureus | |
|---|---|---|---|---|
| J34 | Aspergillus ustus | 80.06 ± 6.22 | 9.45 ± 0.87 | 69.84 ± 5.20 |
| J35 | Aspergillus keveii | 32.21 ± 3.05 | 38.76 ± 1.47 | 27.26 ± 11.61 |
| J36 | Penicillium chrysogenum | 70.72 ± 1.42 | 17.17 ± 0.52 | 82.07 ± 3.93 |
| J42 | Penicillium steckii | 50.66 ± 5.95 | 11.09 ± 0.79 | 17.69 ± 7.32 |
| J47 | Penicillium melinii | 98.56 ± 0.11 | 15.51 ± 0.49 | 32.27 ± 6.72 |
| J48 | Aspergillus ustus | 0.00 ± 0.00 | 7.91 ± 0.18 | 76.84 ± 2.77 |
| J49 | Penicillium citreonigrum | 51.94 ± 5.14 | 10.36 ± 1.67 | 26.80 ± 2.41 |
| J55 | Pseudogymnoascus pannorum | 33.66 ± 8.25 | 8.32 ± 0.32 | 69.24± 6.21 |
| HJ1 | Plectosphaerella cucumerina | 49.20 ± 1.21 | 13.49 ± 1.02 | 74.14 ± 4.04 |
| Endophytes | Amylolytic Activity | Cellulolytic Activity | Esterase Activity | Lipolytic Activity | Proteolytic Activity | |
|---|---|---|---|---|---|---|
| J34 | Aspergillus ustus | 0.00 ± 0.00 | 1.41 ± 0.03 | 1.25 ± 0.08 | 1.11 ± 0.02 | 0.00 ± 0.00 |
| J35 | Aspergillus keveii | 1.31 ± 0.11 | 1.54 ± 0.01 | 1.14 ± 0.04 | 1.52 ± 0.05 | 0.00 ± 0.00 |
| J36 | Penicillium chrysogenum | 0.00 ± 0.00 | 1.34 ± 0.04 | 0.00 ± 0.00 | 0.00 ± 0.00 | 0.00 ± 0.00 |
| J42 | Penicillium steckii | 1.21 ± 0.04 | 1.60 ± 0.03 | 1.33 ± 0.07 | 1.45 ± 0.05 | 2.03 ± 0.05 |
| J47 | Penicillium melinii | 0.00 ± 0.00 | 1.20 ± 0.03 | 1.19 ± 0.04 | 1.63 ± 0.02 | 0.00 ± 0.00 |
| J48 | Aspergillus ustus | 1.13 ± 0.03 | 1.45 ± 0.05 | 0.00 ± 0.00 | 1.19 ± 0.05 | 1.15 ± 0.03 |
| J49 | Penicillium citreonigrum | 0.00 ± 0.00 | 1.24 ± 0.04 | 1.51 ± 0.09 | 2.01 ± 0.08 | 0.00 ± 0.00 |
| J55 | Pseudogymnoascus pannorum | 0.00 ± 0.00 | 1.61 ± 0.04 | 0.00 ± 0.00 | 1.30 ± 0.02 | 1.12 ± 0.03 |
| HJ1 | Plectosphaerella cucumerina | 0.00 ± 0.00 | 0.00 ± 0.00 | 1.17 ± 0.03 | 1.47 ± 0.06 | 0.00 ± 0.00 |
| Endophytes Extracts | Half Maximal Effective Concentration (EC50) (µg/mL) | |
|---|---|---|
| J34 | Aspergillus ustus | 133.59 ± 3.87 |
| J35 | Aspergillus keveii | 52.12 ± 1.10 |
| J36 | Penicillium chrysogenum | 38.53 ± 2.37 |
| J42 | Penicillium steckii | 53.16 ± 1.34 |
| J47 | Penicillium melinii | 23.31 ± 0.61 |
| J48 | Aspergillus ustus | 68.59 ± 2.65 |
| J49 | Penicillium citreonigrum | 54.92 ± 1.25 |
| J55 | Pseudogymnoascus pannorum | 515.95 ± 10.57 |
| HJ1 | Plectosphaerella cucumerina | 26.50 ± 0.80 |
| Endophytes Extracts | % Inhibition of S. aureus | % Inhibition of K. pneumoniae | |
|---|---|---|---|
| J34 | Aspergillus ustus | 100 ± 0.40 | 48.22 ± 2.15 |
| J35 | Aspergillus keveii | 100 ± 0.29 | 32.51 ± 2.82 |
| J36 | Penicillium chrysogenum | 76.86 ± 2.49 | 0.00 |
| J42 | Penicillium steckii | 100 ± 1.67 | 25.70 ± 4.20 |
| J47 | Penicillium melinii | 100 ± 1.12 | 16.30 ± 5.10 |
| J48 | Aspergillus ustus | 100 ± 0.39 | 27.17 ± 2.26 |
| J49 | Penicillium citreonigrum | 100 ± 0.36 | 28.34 ± 2.04 |
| J55 | Pseudogymnoascus pannorum | 100 ± 0.17 | 0.00 |
| HJ1 | Plectosphaerella cucumerina | 100 ± 0.59 | 59.92 ± 4.32 |
| Primer | Sequence (5′ → 3′) | Product Size (bp) | Reference | Amplified Region |
|---|---|---|---|---|
| ITS1 | TCC GTA GGT GAA CCT GCG G | 600 | [80] | ITS region |
| ITS4 | TCC TCC GCT TAT TGA TAT GC | |||
| LROR | ACC CGC TGA ACT TAA GC | 1500 | [83] | 28S ribosomal RNA |
| LR7 | TAC TAC CAC CAA GAT CT | |||
| Bt2a | GGT AAC CAA ATC GGT GCT GCT TTC | 500 | [84] | b-tubulin |
| Bt2b | ACC CTC AGT GTA GTG ACC CTT GGC |
Disclaimer/Publisher’s Note: The statements, opinions and data contained in all publications are solely those of the individual author(s) and contributor(s) and not of MDPI and/or the editor(s). MDPI and/or the editor(s) disclaim responsibility for any injury to people or property resulting from any ideas, methods, instructions or products referred to in the content. |
© 2025 by the authors. Licensee MDPI, Basel, Switzerland. This article is an open access article distributed under the terms and conditions of the Creative Commons Attribution (CC BY) license (https://creativecommons.org/licenses/by/4.0/).
Share and Cite
Borrego, R.; Bódalo, A.; Izquierdo-Bueno, I.; Moraga, J.; Carbú, M.; Bolivar-Anillo, H.J.; Vela-Delgado, M.D.; Cantoral, J.M.; Garrido, C.; González-Rodríguez, V.E. Multifunctional Endophytic Fungi from Ginger (Zingiber officinale) with Antimicrobial, Enzymatic, and Antioxidant Potential. Agronomy 2025, 15, 2711. https://doi.org/10.3390/agronomy15122711
Borrego R, Bódalo A, Izquierdo-Bueno I, Moraga J, Carbú M, Bolivar-Anillo HJ, Vela-Delgado MD, Cantoral JM, Garrido C, González-Rodríguez VE. Multifunctional Endophytic Fungi from Ginger (Zingiber officinale) with Antimicrobial, Enzymatic, and Antioxidant Potential. Agronomy. 2025; 15(12):2711. https://doi.org/10.3390/agronomy15122711
Chicago/Turabian StyleBorrego, Rogelio, Alejandro Bódalo, Inmaculada Izquierdo-Bueno, Javier Moraga, María Carbú, Hernando José Bolivar-Anillo, María Dolores Vela-Delgado, Jesús M. Cantoral, Carlos Garrido, and Victoria E. González-Rodríguez. 2025. "Multifunctional Endophytic Fungi from Ginger (Zingiber officinale) with Antimicrobial, Enzymatic, and Antioxidant Potential" Agronomy 15, no. 12: 2711. https://doi.org/10.3390/agronomy15122711
APA StyleBorrego, R., Bódalo, A., Izquierdo-Bueno, I., Moraga, J., Carbú, M., Bolivar-Anillo, H. J., Vela-Delgado, M. D., Cantoral, J. M., Garrido, C., & González-Rodríguez, V. E. (2025). Multifunctional Endophytic Fungi from Ginger (Zingiber officinale) with Antimicrobial, Enzymatic, and Antioxidant Potential. Agronomy, 15(12), 2711. https://doi.org/10.3390/agronomy15122711

